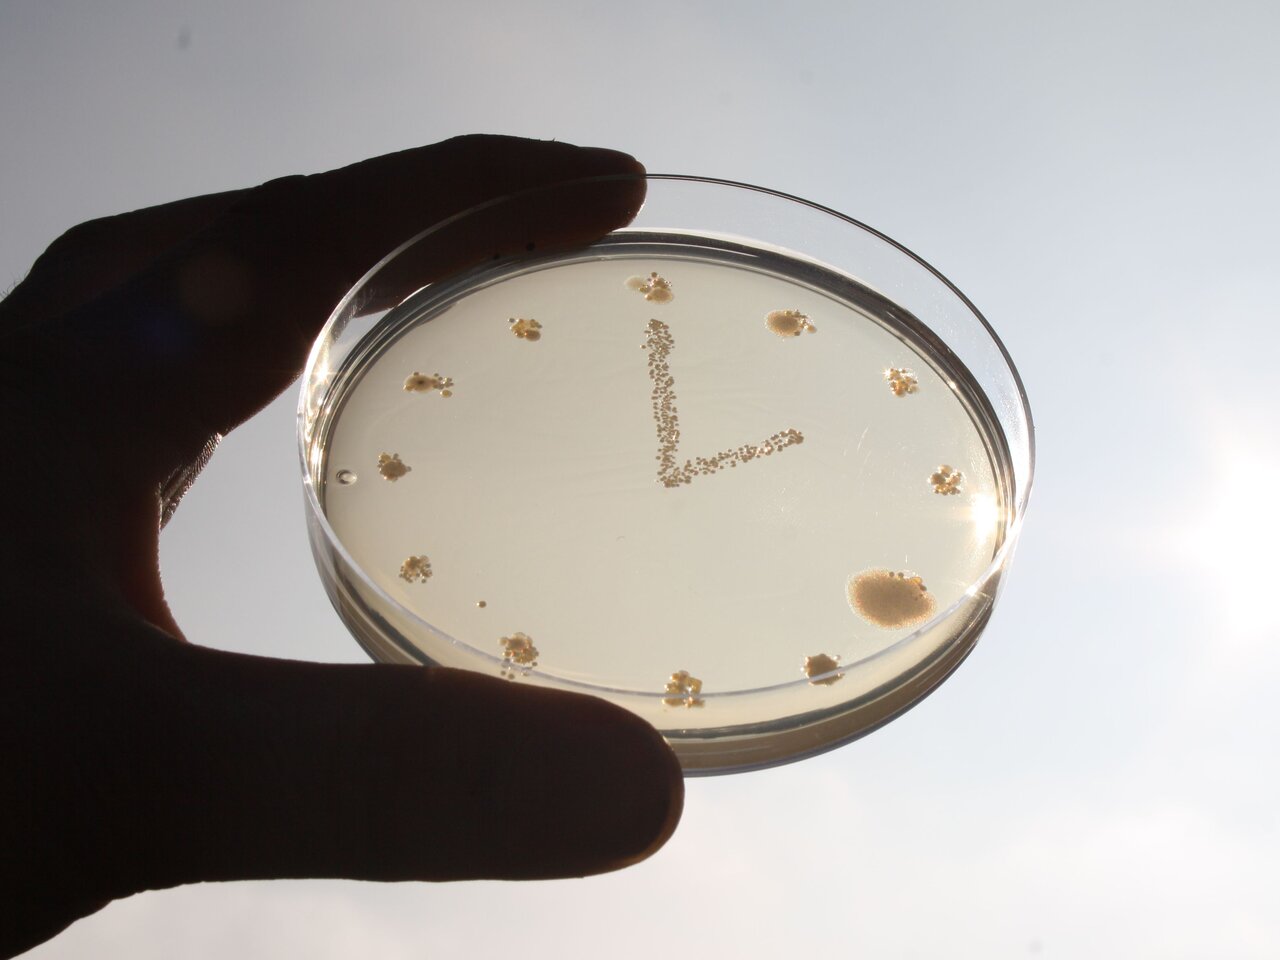

Institut für
AT Agrartechnologie
Projekt
Bioaerosole rund um die Uhr messen
Automatische Messung der Konzentrationsschwankungen von Bioaerosolen an Tierställen im Tagesverlauf
Die Bioaerosolemissionen aus Tierställen scheinen sehr hoch zu sein. Messungen werden jedoch nur tagsüber durchgeführt. Wir erheben mit einem neuartigen Messsystem kontinuierlich Tag und Nacht Daten, um die tatsächliche Höhe der Emissionen zu bestimmen.
Hintergrund und Zielsetzung
Emissionen von Bioaerosolen aus Tierställen schwanken stark, z. B. durch die wechselnde Aktivität der Tiere im Stall. Will man sie richtig messen, muss man dies kontinuierlich tun, auch nachts. Dies tun wir mit Hilfe eines neuartigen Sammelsystems.
Zielgruppe
Um abschätzen zu können, wie Bioaerosol-Emissionen auf die Bevölkerung wirken, braucht man belastbare Daten. Unsere Messungen helfen Landesämtern, Umweltgutachtern und Ingenieurbüros, potentielle Gefahren besser einzuschätzen.
Vorgehensweise
Impinger sind spezielle Waschflaschen, die standardmäßig eingesetzt werden, um Bioaerosole in Salzlösung zu sammeln. Darauf basierend haben wir ein automatisches System entwickelt, mit dem wir bei verschiedenen Tierarten und Haltungssystemen über einen Zeitraum von 48 h kontinuierlich Tagesgänge messen.
Unsere Forschungsfragen
Wie stark schwanken die Konzentrationen von Bioaerosolen an Tierställen im Tagesverlauf?
Ergebnisse
Es gibt einen tageszeitlichen Verlauf mit deutlich geringeren Konzentrationen zu Ruhezeiten. Die Höhe der Schwankungen ist anscheinend neben der Aktivität im Stall auch von der Körperoberfläche der verschiedenen Tierarten abhängig. Die größten Schwankungen, nämlich mehr als eine Zehnerpotenz, haben wir bisher bei Geflügel festgestellt. Bei Ziegen fallen die Schwankungen geringer aus, gefolgt von Rindern und Schweinen. Mögliche Erklärungen dafür wären:
- Geflügel und Ziegen haben im Verhältnis eine größere emittierende Oberfläche (feingliedrige Federn, dichtes Fell)
- Geflügel bewegt sich mehr
- Mikroorganismen gelangen über Federfragmente oder Haare leichter in die Luft
- Federkleid und Fell schützen Mikroorganismen vor Kälte und Austrocknung
Thünen-Ansprechperson

Thünen-Beteiligte
Zeitraum
10.2015 - 12.2018



